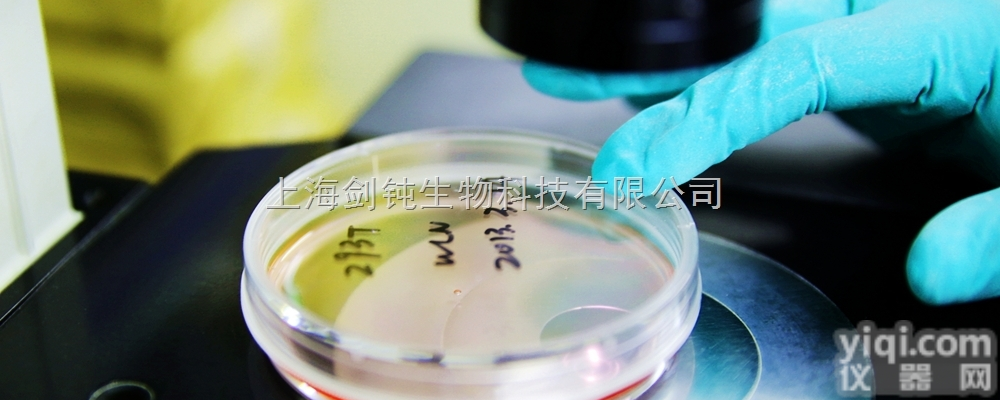
原位<em>杂交</em>病理<em>实验</em>外包

Southern杂交实验
- 产地:其它
- 供应商:上海拜沃生物科技有限公司
- 供应商报价:电议
- 标签:Southern杂交实验,生物试剂,生物制剂,供应Southern杂交实验,上海拜沃生物科技有限公司
| 编号 | 实验项目 | 规格 | 收费标准(元) | 周期 |
| FZ-42 | Southern 杂交 | 每张膜可做 1-8个样品 | 询价 | 20个工作日 |
| FZ-43 | PCR-Southern杂交 | 每张膜可做 1-8个样品 | 询价 | 10个工作日 |
| FZ-44 | Northern杂交 | 每张膜可做 1-4个样品 | 询价 | 20个工作日 |
详情请登入:www.biovol.net